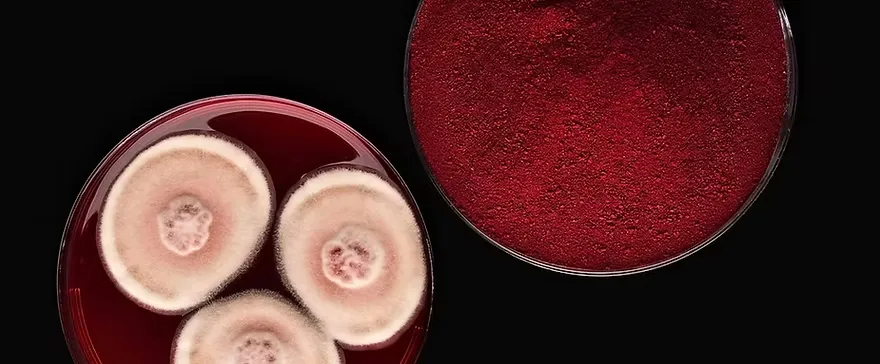
1764582569122253.jpg

Foodaily每日食品整理:Ruoyao Peng
来源:Foodaily每日食品(ID:foodaily)
封面图来源:沃尔玛、味动力、盒马
新产品
1、双柠混搭黄皮!盒马推出「黄皮爆柠茶」新品
2、明星菌株加持!味动力推出「益生菌维矿气泡水」新品
3、低GI新选择!旺旺爱至尊上新「低GI中老年酸奶」
4、添加一整片柠檬!沃尔玛自有品牌沃集鲜上新「鲜切柠檬片苏打汽水」
5、10道工序加持!辻利茶铺推出「抹茶汤圆」新品
公司新闻
6、上半年总收益达111.08亿元!中国旺旺发布2025年中期财报
7、销售额达260亿元!明治控股发布2026财年中期财报
8、收入达29.4亿元!维他奶国际发布2025年中期业绩
9、领导层变更!宗馥莉卸任娃哈哈集团公司董事长
10、14种“三新原料”获批!威尼斯镰刀菌蛋白、接骨木莓花色苷、油橄榄果多酚上榜
11、业务跨界!好特卖入局咖啡赛道
投融资
12、推出基于发酵工艺的天然食品色素!丹麦生物技术公司Chromologics完成5722万元融资

1、双柠混搭黄皮!盒马推出「黄皮爆柠茶」新品
近日,盒马推出「黄皮爆柠茶」新品。据官方介绍,新品选用广东郁南县无核黄皮(黄皮浆≥7.7%),搭配尤力克柠檬和香水柠檬原汁,融合冷萃茉莉花茶底,甜酸爽口,适合佐餐、聚餐等场景。
Foodaily观察到,自2021年喜茶制定了全程冷链+带枝运输的供应方案,解决了黄皮的地域限制以来,黄皮逐渐从传统鲜食水果延伸至饮品原料领域。如今,黄皮已成为新茶饮赛道的热门食材之一,喜茶、古茗、茶百道等多家茶饮品牌都曾推出相关产品,热度持续攀升。另一方面,盒马的此次推新精准符合Flywheel《新零售饮料新品趋势报告》中提出的“街饮品质化”趋势,使得消费者能够在超市中以更便捷的方式获得专业饮品店品质的体验。
目前,新品已上线盒马,售价为9.9元/瓶。

图片来源:盒马
2、明星菌株加持!味动力推出「益生菌维矿气泡水」新品
近日,味动力推出「益生菌维矿气泡水」新品。据官方介绍,新品添加8种维生素矿物质(维生素B6、B12、C、E和钙、镁、锌、烟酸),搭配4种均瑶健康明星菌株(J26植物乳植杆菌、JL-1鼠李糖乳酪杆菌、BL-G101动物双歧杆菌乳亚种、嗜酸乳杆菌),同时采用0脂低卡配方,适合运动、佐餐等场景。
根据PeopleSearch发布的《2025消费行业年度趋势报告》,2024年益生菌类产品销售额增长40%。此次推新,也是均瑶健康自2021年宣布向“益生菌+X”赛道“二次创业”战略布局的再次延伸,与其首席科学官叶育彬在2025年4月提出的“功能营养日常化”理念高度契合,通过“维生素矿物质+益生菌+气泡水”的创新组合,将益生菌从传统乳酸菌饮品拓展至更广阔的气泡水赛道。
目前,新品已上线官方微信店铺,售价为500ml*15瓶/69元。

图片来源:味动力
3、低GI新选择!旺旺爱至尊上新「低GI中老年酸奶」
近日,旺旺爱至尊上新「低GI中老年酸奶」。据官方介绍,新品添加26亿乳酸菌,且0蔗糖0乳糖,高膳食纤维(6g/包),GI值约为49。
根据国际糖尿病联盟(IDF)估算,我国65岁以上糖尿病患者数量已从2019年的3500万上升到2024年的4790万,预计2025年将攀升至7660万。在此背景下,低GI食品市场呈现强劲增长的趋势,叮咚买菜数据显示,2024年中国低GI食品市场规模已突破1300亿元,预计2030年将达2000亿元,显示出中老年低GI食品赛道的巨大潜力。同时旺旺此次推新,与7月发布的《中老年人群用低GI食品》团体标准及其参加的第七届中国GI国际会议所倡导的理念高度一致,体现了品牌对市场需求与科学共识的积极响应。
目前,新品已上线淘宝爱至尊旗舰店,售价为125ml*16盒/78元。

图片来源:爱至尊
4、添加一整片柠檬!沃尔玛自有品牌沃集鲜上新「鲜切柠檬片苏打汽水」
近日,沃集鲜上新「鲜切柠檬片苏打汽水」。据官方介绍,新品添加一整片鲜切四川安岳柠檬,0糖0脂0卡,配料干净,同时采用全开盖设计,方便加入配料特调,适合火锅、户外等场景。
去年日本朝日啤酒推出的「未来的柠檬沙瓦」作为全球首款含真实柠檬片的即饮鸡尾酒,其开罐即见悬浮柠檬片的设计引发市场热烈反响,试售期间两周内即售罄1,700套(总计10,200瓶)。沃集鲜的此次推新,将这一产品思路延伸到了苏打汽水中,与其近期提出的“简单为鲜,沃集鲜”核心理念高度契合,实现了“简单配料、原料鲜、产地鲜”,进一步强化了沃尔玛通过自有品牌升级构建差异化商品力的转型。
目前,新品已上线沃尔玛,售价为310ml*6瓶/14.99元。

图片来源:沃尔玛
5、10道工序加持!辻利茶铺推出「抹茶汤圆」新品
近日,辻利茶铺推出「抹茶汤圆」冬季限定新品。据官方介绍,新品内馅采用辻利抹茶粉,经过覆下栽培、蒸汽杀青、研磨等10道工序制成,含有茶氨酸、茶多酚等营养元素;外皮由产自北纬第一积温带的东北五常市糯米,经过古法水磨工艺制成,口感细腻。无需解冻,沸水煮6分钟即可食用。
根据QYResearch数据,2024年全球抹茶市场销售额达3.6亿美元,预计到2031年将增长至6.12亿美元,期间年复合增长率(CAGR)达8.0%,反映出全球消费者对抹茶认可度的持续提升。事实上,早在2017年,辻利茶铺与桂冠联名推出的抹茶汤圆就曾创下销售60万盒的亮眼成绩,成为备受关注的联名产品。此次辻利茶铺再度推出抹茶汤圆新品,延续了品牌在抹茶食品化创新上的成功路径,有助于进一步提升其市场占位。
目前,新品已上线淘宝官方旗舰店,售价为160g*2盒/99元。

图片来源:辻利茶铺

6、上半年总收益达111.08亿元!中国旺旺发布2025年中期财报
11月24日,中国旺旺发布截至2025年9月30日止六个月中期业绩,总收益为111.08亿元,较上一财年同期增长2.1%。按分部业务来看,涵盖旺仔QQ糖、牛奶糖、泡芙等产品的休闲食品业务,实现营收29.40亿元,与去年同期相比增长了7.7%。包括旺旺碎冰冰的冰品业务,实现了中双位数的增长。米果类业务方面,像旺旺雪饼、小小酥等产品,营收达到21.3亿元,同比增长3.5%,并且毛利率反而提升了1.3个百分点。
据财报披露,新兴渠道、零食量贩和海外市场正成为旺旺的重要增长引擎。其中,新兴渠道取得优异表现,收益较上一财年同期成长达双位数,占集团总收益比已逾10%。同时,零食量贩收益较上一财年同期高速成长,占集团收益比已达約15%。

图片来源:旺旺
7、销售额达260亿元!明治控股发布2026财年中期财报
近日,明治控股发布截至2026年3月的财年中期财务业绩,报告显示,销售额同比增长1.0%至5748.85亿日元(折合人民币约260亿元),但营业利润下降7.8%至409.42亿日元(折合人民币约18.5亿元),归属于母公司所有者的中期净利润下降20.1%至214.77亿日元(折合人民币约9.7亿元)。食品业务的销售额和利润均有所增长,但受到制药业务利润下滑的影响,公司已下调全年销售额预期,但各利润板块的预期保持不变。
在日常食品业务(益生菌、酸奶、牛奶、海外)方面,销售额与去年同期持平。在日本国内,得益于价格调整和加强促销,主力产品"明治保加利亚酸奶"和"明治美味牛奶"等零售产品销售表现良好,但由于配送渠道销售不振,整体销售额与去年同期持平。而海外市场,自2025年7月起在中国推出新品"明治美味牛奶",零售用牛奶及酸奶业务收入增长,营业利润大幅超过去年同期。
在糖果业务(巧克力、软糖、海外)方面,销售额超过去年同期。在日本国内,巧克力业务因价格调整效果实现收入增长,软糖业务也因新品销售表现良好而收入增长。海外市场得益于中国主力巧克力系列的增长以及美国"Hello Panda"产品的销售扩大,收入有所增长。

图片来源:明治控股
8、收入达29.4亿元!维他奶国际发布2025年中期业绩
11月25日,维他奶国际发布截至2025年9月30日止六个月的业绩公告。公司在中期财务期间录得收入为32.27亿港元(折合人民币约29.4亿元),较去年同期减少6%。毛利为16.48亿港元(折合人民币约15亿元),下降7%,毛利率轻微下跌至51.1%。收入减少主要由于中国内地业务受市况疲弱影响,面临挑战。
报告期内,中国内地仍是该集团的最大市场,占集团总收入的55%。受到内地传统零售渠道收入收缩以及植物奶、即饮茶品类增长放缓等影响,上半财年中国内地业务实现收入17.78亿港元(折合人民币约19.53亿元),同比下降9%;实现经营溢利1.91亿港元(折合人民币约2.09亿元),去年同期为2.18亿港元(折合人民币约2.39亿元)。维他奶集团执行主席罗友礼在业绩会上介绍,中国内地市场植物奶品类及即饮茶类别的年度增长率有所放缓,其中植物奶跌幅近10%,即饮茶则从去年的双位数增长放缓至今年约增长5%,这部分增长主要由无糖茶带动。

图片来源:维他奶国际
9、领导层变更!宗馥莉卸任娃哈哈集团公司董事长
近日,杭州娃哈哈集团有限公司发生工商变更,宗馥莉卸任法定代表人、董事长、总经理职务,由许思敏接任,同时,多位主要人员发生变更。据悉,目前宗馥莉仍持有杭州娃哈哈集团29.40%的股权。
据媒体此前报道,宗馥莉已于9月12日向娃哈哈集团正式提交辞职申请,辞去公司法定代表人、董事及董事长等核心职务,并已通过集团股东会和董事会的相关程序。同时有公开报道显示,自宗馥莉2024年8月接班娃哈哈后,许思敏就被提拔进入权力核心,担任娃哈哈集团监事,并任多家关联公司法定代表人、总经理。今年10月,宗馥莉辞去娃哈哈集团董事长后,许思敏被任命为集团总经理。
10、14种“三新原料”获批!威尼斯镰刀菌蛋白、接骨木莓花色苷、油橄榄果多酚上榜
11月27日,卫健委食品安全标准与监测评估司发布2025年第7号公告,批准威尼斯镰刀菌蛋白、接骨木莓花色苷、油橄榄果多酚为新食品原料。
同时批准或扩大应用食品营养强化剂新品种,如β-丙氨酸、(6S)-5-甲基四氢叶酸、氨基葡萄糖盐、6S-5-甲基四氢叶酸钙、食品添加剂甜菊糖苷(酶转化法)、食品营养强化剂 2’-岩藻糖基乳糖、碳酸钙(海藻来源)等。
本次获批的多种新原料和添加剂,如威尼斯镰刀菌蛋白、甜菊糖苷(酶转化法)等,此前在美国、欧盟等多个国家和地区已被批准使用,这表明我国的食品原料审批正积极与国际标准接轨。

图片来源:国家卫健委
11、业务跨界!好特卖入局咖啡赛道
近日,好特卖在上海部分门店悄然上线咖啡业务,售卖多款现制咖啡产品,美式咖啡低至3.9元的售价引发市场关注。作为折扣零售品牌,好特卖此举被外界解读为继拓展超级仓业态后的又一跨界尝试。
从业务逻辑看,好特卖的咖啡布局带有明显引流属性。依托现有门店网络,采用“店中店”模式,仅需增设小型制作区与咖啡机,单店启动成本远低于独立咖啡品牌。这一模式有助于降低选址与租金压力,提升坪效。长期来看,“临期食品”标签制约了好特卖的品牌升级空间。咖啡作为生活方式型品类,具备重塑品牌形象的潜力。

12、推出基于发酵工艺的天然食品色素!丹麦生物技术公司Chromologics完成5722万元融资
近日,丹麦生物技术公司Chromologics完成700万欧元(折合人民币约5722万元)的新一轮融资,本轮由诺和诺德基金会、丹麦出口投资基金、Döhler Ventures公司、Collateral Good Ventures及Synergetic共同领投。此次融资将用于推动其天然红色素产品Natu.Red获得欧盟食品安全局(EFSA)与美国食药监局(FDA)的监管批准,同时通过大型合同生产合作伙伴实现规模化生产。
Chromologics 是丹麦技术大学的衍生公司,致力于开发基于发酵工艺的天然色素,据官方介绍这些色素具有耐热性和 pH 值稳定性,适合素食主义者使用,且不受季节性农业限制。欧美地区超过90家食品生产商的试验数据显示,其产品在肉类加工、糖果制造及植物基产品等应用中均表现出色。
投资机构的关注反映出市场对合成色素的天然替代品需求日益增长,特别是在美国近期加强对人工红色素监管审查的背景下。Döhler Ventures 的董事 Rodrigo Hortega de Velasco 表示,面对监管变化和消费需求升级,Chromologics 的技术为食品生产商提供了一种“稳定、可扩展且具有成本优势的解决方案”。
图片来源:Chromologics



















